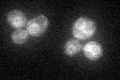
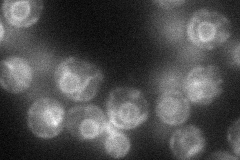
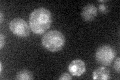

View description
ER membrane localized phosphoryltransferase that adds phosphoethanolamine onto the third mannose residue of the glycosylphosphatidylinositol (GPI) anchor precursor; similar to human PIG-O protein
Localization:
Intensity:
Fold change:
Significance:
-
C’ GFP library in SD
ER35.51 -
N' NOP1pr-GFP in SD
ER50.0742 -
N' TEF2pr-mCherry in SD

ER61.3236 -
N' NATIVEpr-GFP in SD

ER28.699 -
N' TEF2pr-VC and Cyto-VN in SD

ER31.4833 -
C’ GFP library in SD+DTT

technical problem0N/ANo -
C’ GFP library in SD+H2O2

ER40.731.14No -
C’ GFP library in Starvation Media
ER31.890.89No -
C’ GFP library on the background of Pup2-DaMP

ER -
C’ GFP library on the background of CCT mutant

ER29.92180.842413No
